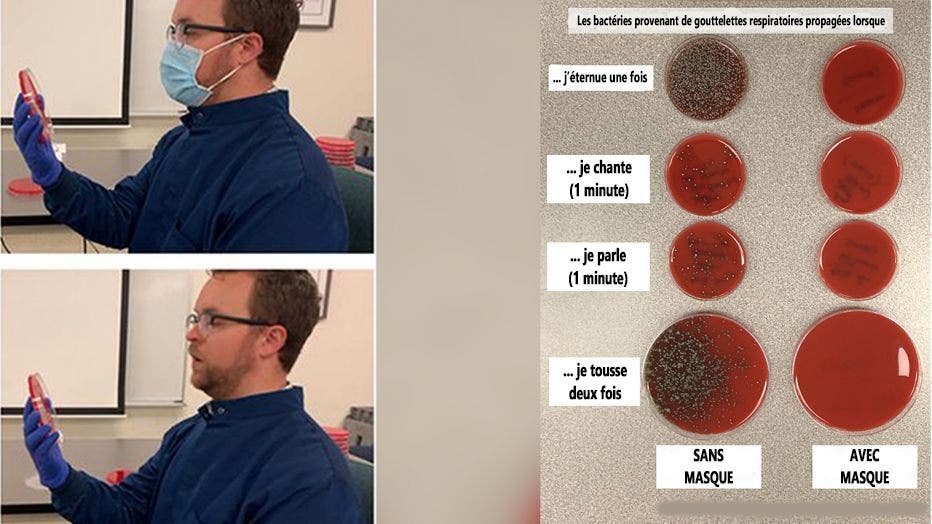
richard davis test

Coronavirus : Si vous doutez encore de l’efficacité des masques, il suffit de regarder la démonstration de ce microbiologiste

Depuis quelques mois déjà, la planète toute entière fait face à une crise sanitaire d’envergure. À l’origine de cette pandémie se trouve un nouveau coronavirus, découvert en Chine, plus précisément à Wuhan. Responsable de la maladie du Covid-19, le Sars-CoV-2 s’est propagé à une vitesse inattendue dans les quatre coins du monde. Si certains restent sceptiques face à l'utilité des masques, un microbiologiste a publié une illustration pour démontrer l’efficacité de ce moyen de protection. Ses explications ont été relayées par Fox6 Now.
Pour enrayer la transmission du nouveau coronavirus, plusieurs gouvernements ont opté pour le confinement des populations pendant un certain temps. De nombreux pays ont imposé à leurs habitants le port du masque dans les espaces publics lors des déplacements obligatoires.
En France, la pénurie de masques avait fait l’objet d’une véritable “scandale d’État”, provoquant l’indignation du personnel soignant, mais aussi des citoyens, indique France Inter.
Fort heureusement, la levée du confinement dans l’Hexagone s’est faite en toute sécurité, avec un stock de masques suffisant pour couvrir les besoins de la population française. Toutefois, les interrogations portant sur l’efficacité des masques persistent encore. Pour trancher, un microbiologiste américain a publié une illustration très intéressante.
Une démonstration
Richard Davis, directeur du laboratoire de microbiologie clinique au Providence Sacred Heart Medical Center à Washington, a réalisé une première expérience pour démontrer l’utilité des masques pendant cette crise. Son objectif ? Évaluer l’efficacité du masque pour bloquer les gouttelettes respiratoires émises par une personne.
Pour ce faire, Richard Davis a utilisé des boîtes de Pétri afin de réaliser une mise en culture bactérienne et d’étudier les germes qui vont s’y répandre. Il a d’abord toussé, parlé, chanté puis éternué dans une plaque de culture avec un masque de protection de type chirurgical pour montrer le nombre de gouttelettes respiratoires qui atterrissent sur la surface. Ensuite, il a réitéré l’expérience, cette fois-ci sans masque de protection.
Le milieu de culture choisi contenait de l’agar agar, une substance gélatineuse couramment utilisée en microbiologie pour cultiver les micro-organismes.
Après avoir finalisé son expérience, le microbiologiste a obtenu des résultats qui selon lui, mettent en exergue l’importance du masque pour se protéger contre les agents pathogènes. Le spécialiste a comparé la formation des bactéries dans les boîtes de Pétri avec et sans le masque. “Les colonies de bactéries montrent où les gouttelettes ont atterri.
Un masque les bloque pratiquement toutes”, a révélé le chercheur. En effet, les images montrent que sans masque, les bactéries se formaient dans les boîtes, notamment lorsqu’on tousse ou qu’on éternue. À contrario, le masque semble efficace pour freiner la propagation des micro-organismes.
Dans une deuxième démonstration, Richard Davis a voulu évaluer l’efficacité de la distance sociale comme moyen de protection contre le coronavirus. Il a alors éloigné les boîtes de Pétri à 0,6 mètre, puis à 1,2 mètre et enfin à 1,8 mètre, puis a toussé fort avec et sans le masque pour effectuer une comparaison.

foxtv
Les résultats ont révélé que peu importe la distance, le masque ralentissait considérablement la propagation bactérienne. Sans le masque, une distance de 1,8 mètre pouvait freiner la transmission des bactéries.
Le port du masque ne suffit pas à se protéger contre le virus
Richard Davis révèle que ses critiques insistent sur le fait que les virus et les bactéries ne se valent pas. En effet, le microbiologiste avance des résultats qui ne portent pas sur un virus. Mais il insiste néanmoins sur le fait que ces observations sont en principe comparables et que les masques peuvent être efficaces contre l’ensemble de ces micro-organismes, indique Business Insider.
William Schaffner, professeur en médecine préventive et maladies infectieuses nuance cet avis tout en validant son point de vue. “Utiliser des masques de plusieurs types, la distanciation sociale ou éviter les rassemblements etc, voilà les choses qui, lorsqu’elles sont cumulées, ont démontré qu’elles pouvaient considérablement réduire les risques de transmission si on les pratique en même temps”.
“Le masque ne remplace pas la distanciation physique, l’hygiène des mains et les autres mesures de santé publique. Le masque n’est utile que dans le cadre d’une approche globale de la lutte contre la Covid-19”, rappelle Tedros Adhanom Ghebreyesus, directeur général de l’OMS. Pour une protection optimale contre l’infection virale, il est nécessaire de respecter les principes suivants:
– Se laver régulièrement les mains à l’eau et au savon et utiliser du gel hydroalcoolique
– Maintenir une distance d’au moins 1 mètre avec autrui
– Ne pas se toucher les yeux, le nez et la bouche
– Lors d’un éternuement ou d’un épisode de toux, la personne doit se couvrir la bouche et le nez avec le pli du coude ou un mouchoir jetable.